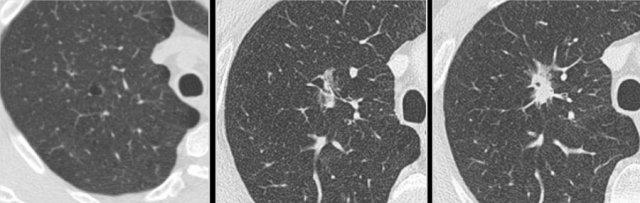
Example showing transition from cystic (left and middle panel) to part-solid lung cancer morphology (right panel).

Ung thư phổi dạng nang
Ung thư phổi nguyên phát dạng nang ngày càng được công nhận là một hình thái học hình ảnh đặc trưng.
Trong bài viết này, chúng tôi sẽ thảo luận về các đặc điểm hình ảnh và hướng xử trí.
Nhấn ctrl+ để phóng to hình ảnh và văn bản trên PC hoặc ⌘+ trên Mac.
Hầu hết các hình ảnh có thể được phóng to riêng lẻ bằng cách nhấp vào chúng.
Giới thiệu
Ung thư phổi nguyên phát dạng nang thường bị bỏ sót hoặc chẩn đoán nhầm, điều này nhiều khả năng là do hình ảnh đặc trưng của chúng, có sự chồng lấp với các bệnh lý lành tính như nhiễm trùng.
Hình ảnh của loại này khác biệt so với các nốt đặc và nốt bán đặc, vốn là những hình thái CT phổ biến hơn của ung thư phổi (hình).
Thuật ngữ

Ví dụ về ung thư phổi dạng nang với thành phần đặc hướng ngoại (bảng trái) và hướng nội (bảng phải).
Nốt phổi dạng nang có thể được định nghĩa là vùng đậm độ đặc và/hoặc kính mờ liên quan đến một khoang khí nhu mô có ranh giới rõ.
Nốt dạng nang có thể biểu hiện:
- Thành phần đặc hướng ngoại hoặc hướng nội tiếp giáp với khoang khí dạng nang (hình).
- Dày thành không đều, một phần hoặc toàn chu vi.
- Hình ảnh phức tạp với các thành phần bán đặc và các khoang khí đa thùy.
Các hình ảnh minh họa thêm các ví dụ về ung thư phổi dạng nang với dày thành không đều mỏng (bảng trái) và dày (bảng giữa), cùng hình ảnh phức tạp hơn với kính mờ lan rộng và các khoang khí đa thùy (bảng phải).
Một số hệ thống phân loại đã được đề xuất dựa trên hình thái học hình ảnh này [1,2].
Ý nghĩa lâm sàng của bất kỳ hệ thống phân loại phụ nào vẫn chưa được xác định, do đó giá trị ứng dụng trong thực hành chẩn đoán hình ảnh thường quy còn hạn chế.
Đặc hóa
Đặc hóa là quá trình ngược lại với tạo hang.
Đặc hóa là một quá trình thường gặp trong ung thư phổi dạng nang – trong đó thành phần mô đặc tăng dần theo thời gian và cuối cùng có thể lấp đầy hoàn toàn các khoang kính mờ và/hoặc khoang khí dạng nang trước đó, dẫn đến hình thành một khối đặc.
Đây là một ví dụ khác về ung thư phổi dạng nang biểu hiện quá trình ‘đặc hóa’, từ tổn thương tiền thân ban đầu với dày thành không đều kín đáo tiến triển thành một khối đặc tại thời điểm chẩn đoán.
Cần lưu ý rằng tạo hang – là quá trình hình thành vùng sáng trung tâm do tống xuất nội dung hoại tử của khối u – chỉ có thể được đánh giá trên CT theo dõi theo thời gian.
Mặc dù thuật ngữ này rất thường gặp trong các báo cáo CT tại một thời điểm duy nhất, nhưng cần thận trọng khi sử dụng.
Việc dùng thuật ngữ này có thể gợi ý chẩn đoán phân biệt với nhiễm trùng hoặc các bệnh lý khác, dẫn đến sai lệch khỏi chẩn đoán đúng là ung thư phổi nguyên phát, nhiều khả năng là ung thư biểu mô tuyến [3,4].
Các hình ảnh minh họa một ví dụ khác về ung thư phổi dạng nang biểu hiện quá trình ‘đặc hóa’.
Thực hành lâm sàng hàng ngày

Bệnh nhân ung thư biểu mô tuyến T1c ở thùy trên phổi trái (hình bên trái). Tổn thương dạng nang đồng thời đang phát triển ở thùy dưới phổi phải (hình bên phải) được xác định là ung thư biểu mô tuyến nguyên phát thứ hai không liên quan trên kết quả mô bệnh học. Trong thực hành lâm sàng hàng ngày
Tỷ lệ hiện mắc của ung thư phổi dạng nang chưa được xác định rõ ràng, dao động trong khoảng từ 0,5% đến 12%, tùy thuộc vào tiêu chí lựa chọn quần thể nghiên cứu [1,5,6].
Có thể nhận định rằng hình thái ung thư phổi dạng nang không phải là hiếm gặp [4].
Một số mối liên quan đã được ghi nhận có tầm quan trọng đặc biệt đối với các bác sĩ chẩn đoán hình ảnh trong thực hành đọc phim CT hàng ngày, đòi hỏi sự nhận thức nâng cao và tìm kiếm chủ động trong nhóm bệnh nhân này.
Thứ nhất, đã được ghi nhận rằng ung thư phổi dạng nang thường đại diện cho một khối ác tính nguyên phát thứ hai, có thể xuất hiện không đồng thời (metachronous) hoặc đồng thời (synchronous) với ung thư phổi đầu tiên (hình minh họa).
Thứ hai, một tỷ lệ cao bệnh nhân ung thư phổi dạng nang là người đang hoặc đã hút thuốc lá và có khí phế thũng từ trước, mặc dù ung thư phổi dạng nang không thể phủ nhận cũng xảy ra trên nền phổi hoàn toàn bình thường.
Thứ ba, ung thư phổi dạng nang có xu hướng xuất hiện ở ngoại vi của phổi, khiến đây trở thành một thực thể bệnh lý liên quan đến tất cả các bác sĩ chẩn đoán hình ảnh có chụp một phần phổi trong khảo sát, đặc biệt là các bác sĩ chẩn đoán hình ảnh thần kinh, bụng và cấp cứu.
Các hình ảnh này thuộc về một bệnh nhân có ung thư biểu mô tế bào vảy dạng nang ở thùy dưới phổi trái (hình bên trái), người đã xuất hiện tổn thương dạng nang ở thùy dưới phổi phải (hình bên phải) và hạch bạch huyết to vùng dưới carina sau 3 năm theo dõi.
Mặc dù ban đầu được xem xét là bệnh di căn đối bên, phân tích mô học được khuyến nghị đã cho thấy đây là ung thư biểu mô tế bào vảy nguyên phát thứ hai không liên quan trên kết quả mô bệnh học.
Mô bệnh học
Ung thư phổi dạng nang chủ yếu là ung thư biểu mô tuyến, chiếm khoảng 80% các trường hợp, trong đó ung thư biểu mô tế bào vảy là phân nhóm phổ biến thứ hai.
Một số ít các loại khối u khác như ung thư biểu mô tuyến-vảy, ung thư thần kinh nội tiết và u lympho cũng đã được ghi nhận.
Nhiều cơ chất mô bệnh học nền tảng (ví dụ: tăng sinh khối u khu trú, xơ hóa, tăng trưởng khối u dạng lepidic dọc theo thành phế nang, khí phế thũng) có liên quan đến các đặc điểm hình ảnh của ung thư phổi dạng nang và chịu trách nhiệm tạo ra thành phần đặc, các vách ngăn, kính mờ và các khoang khí dạng nang [1,5,7].
Cơ chế được trích dẫn rộng rãi nhất về sự hình thành khoang khí là thông khí kiểu “van một chiều” (check-valve).
Không khí có thể đi vào trong thì hít vào nhưng không thể thoát ra trong thì thở ra do tắc nghẽn một phần đường thở tận cùng ở phía gần khoang khí dạng nang, gây ra bởi các tế bào khối u và xơ hóa.
Điều này dẫn đến sự hình thành, tồn tại và mở rộng của khoang khí dạng nang.
Tương quan hình ảnh học – mô bệnh học của ung thư biểu mô tế bào vảy.
Một khoang khí dạng nang được lót bởi các tế bào khối u (dấu hoa thị) nhiều khả năng đại diện cho một đường thở xa bị giãn rộng.
Cơ chế thông khí van một chiều do hẹp đường thở ở phía gần hơn bởi các tế bào ác tính và/hoặc xơ hóa được cho là nguyên nhân.
Một động mạch phổi kề cận với các tế bào ác tính bao quanh nhô vào trong lòng mạch (mũi tên).
Diễn tiến tự nhiên

Ví dụ minh họa sự chuyển đổi từ hình thái kính mờ thuần túy (bảng trái) sang hình thái ung thư phổi dạng nang (bảng phải).
Ung thư phổi dạng nang là các tổn thương có xu hướng tiến triển, vốn là đặc tính của căn nguyên ác tính.
Mặc dù có thể có diễn tiến xâm lấn, nhiều trường hợp là các ung thư biểu mô tuyến phát triển khá chậm.
Hình thái trên CT có thể duy trì dạng nang theo thời gian; tuy nhiên, khi sự đóng góp độc lập của các cơ chất mô bệnh học nền thay đổi, hình thái tổn thương cũng có thể biến đổi theo thời gian.
Ví dụ minh họa sự chuyển đổi từ hình thái dạng nang (bảng trái và giữa) sang hình thái ung thư phổi bán đặc (bảng phải).
Các nốt dạng nang có thể biểu hiện sự gia tăng thành phần đặc, xuất hiện thêm thành phần kính mờ và thành phần nang, đồng thời thể tích tổn thương tổng thể cũng tăng lên.
Các nghiên cứu hồi cứu đã chứng minh rằng ung thư phổi dạng nang có thể phát triển từ các tổn thương tiền thân bán đặc kích thước nhỏ, cũng như có thể chuyển đổi từ các tổn thương tiền thân dạng nang thành ung thư đặc hoặc bán đặc tại thời điểm chẩn đoán.
Do đó, hình thái ung thư phổi mang tính linh hoạt và các thành phần dạng nang có thể chỉ là tạm thời.
Ví dụ này minh họa sự chuyển đổi từ hình thái bán đặc (bảng trái), sang hình thái dạng nang tạm thời (bảng giữa), rồi đến hình thái ung thư phổi đặc (bảng phải).
Các bệnh lý dễ nhầm lẫn
Có nhiều bệnh lý lành tính có thể có hình ảnh tương tự ung thư phổi nguyên phát dạng nang, bao gồm [3,4,8]:
- Nhiễm trùng (vi khuẩn, u hạt và nấm)
- Viêm mạch máu
- Viêm khớp dạng thấp
- Amyloid
- Di căn, v.v.
Hình ảnh trước đó (bao gồm cả hình ảnh ngoài lồng ngực), thông tin lâm sàng, các giá trị xét nghiệm cũng như tiền sử bệnh thường rất hữu ích trong việc phân biệt ung thư phổi nguyên phát nghi ngờ với các nguyên nhân khác.
Trong trường hợp không có nguyên nhân lành tính rõ ràng, bất kỳ nang phổi mới xuất hiện hoặc khoang khí dạng nang kèm theo thành phần bán đặc đều cần nâng cao nghi ngờ ác tính phổi nguyên phát và xử trí phù hợp bằng theo dõi CT hoặc sinh thiết, nếu thích hợp.

Các bệnh lý dễ nhầm với ung thư phổi dạng nang: Khoang khí khu trú dai dẳng – hình bên trái, nốt dạng thấp – hình ở giữa và sẹo – hình bên phải.
Các hình ảnh là những ví dụ về các bệnh lý có hình thái dễ nhầm lẫn với ung thư phổi dạng nang.
- Khoang khí khu trú dai dẳng sau tràn khí màng phổi tự phát và phẫu thuật cắt hình nêm tiếp theo (hình bên trái)
- Nốt dạng thấp ở bệnh nhân có tổn thương phổi và màng phổi do viêm khớp dạng thấp (hình ở giữa)
- Tổn thương phổi tình cờ phát hiện, đại diện cho các thay đổi mạn tính và sẹo mà không có dấu hiệu nhiễm trùng hoạt động hoặc ác tính (hình bên phải)
Nguy cơ ác tính tuyệt đối của các nốt dạng nang đơn độc hiện vẫn chưa được xác định, vì điều đó đòi hỏi phải theo dõi tiến cứu tất cả các nốt dạng nang lành tính và ác tính trong một nhóm nghiên cứu nhất định.
Quản lý nốt phổi

Tổn thương dạng nang đa thùy (hình bên trái) được diễn giải là “không đặc hiệu”, mặc dù CT theo dõi sau 6 tháng (vì lý do khác) cho thấy mức độ kính mờ, các khoang khí dạng nang và kích thước tổn thương tổng thể tăng nhẹ. CT tiếp theo được thực hiện do đau ngực 2 năm sau, cho thấy một khối lớn xâm lấn thành ngực (hình bên phải). Bệnh nhân tử vong do ung thư biểu mô tuyến phổi di căn.
Các hướng dẫn quản lý nốt phổi hiện hành dành cho tầm soát (Lung-RADS) hoặc lâm sàng (BTS và Fleischner) chưa bao gồm các nốt phổi dạng nang.
Mặc dù chưa có hướng dẫn thống nhất và chiến lược theo dõi tối ưu vẫn chưa được xác định, điều quan trọng là các tổn thương này không được bỏ sót trong quá trình theo dõi nhằm tránh chậm trễ chẩn đoán và gánh nặng liên quan cho bệnh nhân.
Trong khi chờ đợi khả năng được đưa vào các phiên bản hướng dẫn trong tương lai, chiến lược sau đây có thể hợp lý khi phát hiện một nốt dạng nang nghi ngờ:
- Loại trừ tăng trưởng nhanh trên CT theo dõi sau 3 tháng
- Tiếp tục theo dõi bằng CT ngực hàng năm liên tiếp trong 5 năm, tương tự như theo dõi nốt bán đặc.
- Cân nhắc theo dõi hai năm một lần nếu tổn thương ổn định và thành phần đặc chỉ rất nhỏ hoặc không đo được, tương tự như theo dõi nốt kính mờ thuần túy.
Các hình ảnh cho thấy một tổn thương tiền thân dạng nang nhỏ (hình bên trái) ban đầu được diễn giải là “hang thành mỏng, nhiều khả năng do nhiễm trùng”.
CT tiếp theo được thực hiện do ho 4 năm sau, cho thấy ung thư biểu mô tế bào vảy giai đoạn T4 (hình bên phải).
Bệnh nhân còn sống 2 năm sau phẫu thuật cắt bỏ và điều trị toàn thân.
Phân giai đoạn

Khả năng đánh giá quá mức gánh nặng khối u do tính cả thành phần khoang khí dạng nang vào kích thước tổn thương tổng thể, khi đo theo phân loại TNM ấn bản thứ 8 (đường nét đứt). Đường liền nét (hình bên trái) có thể phản ánh chính xác hơn thành phần khối u xâm lấn và tiên lượng liên quan.
Mặc dù ung thư phổi dạng nang có hình thái học đặc trưng, việc phân giai đoạn vẫn được thực hiện theo phân loại TNM ‘tiêu chuẩn’ ấn bản thứ 8th, vốn phân tầng các nhóm bệnh nhân dựa trên tiên lượng của họ.
Tuy nhiên, việc đo các tổn thương nang phức tạp trên CT có thể dễ xảy ra sai số, và có thể đặt ra giả thuyết rằng kích thước tổn thương tổng thể (bao gồm cả thành phần nang đôi khi rất lớn) sẽ đánh giá quá mức gánh nặng khối u thực sự, do thành phần đặc xâm lấn mới là yếu tố có liên quan nhiều hơn đến tiên lượng.
Việc xem xét trong tương lai về một hệ thống phân loại điều chỉnh là hợp lý, tương tự như hệ thống hiện có dành cho các bệnh ác tính phổi dạng bán đặc [9].










